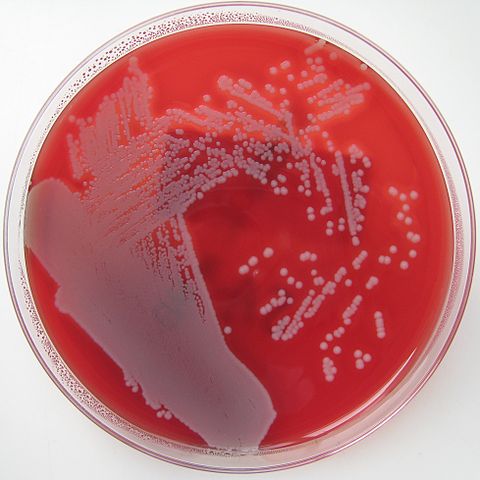

¿Qué es el agar sangre?
El agar sangre es un medio de cultivo sólido enriquecido, utilizado para la recuperación y crecimiento de una gran variedad de microorganismos provenientes de muestras clínicas o para subcultivos.
Este medio de cultivo se compone básicamente de un agar base enriquecido y 5% de sangre ovina. La base de agar puede variar de acuerdo a las necesidades, pero principalmente estará compuesto por peptonas, aminoácidos, vitaminas, extracto de carne, cloruro de sodio, agar, entre otros. En cuanto a la sangre, en ocasiones se usa sangre humana.
El medio agar sangre puede ser preparado en el laboratorio o puede comprarse ya listo, a empresas que se dedican a ello. La preparación de este medio es muy delicada, cualquier descuido en su elaboración dará como resultado un lote contaminado.
Por ello deben tomarse todas las precauciones posibles y al final realizar un control de calidad incubando a 37 °C 1 placa por cada 100 que se preparen.
Fundamento
El agar sangre es un medio enriquecido, diferencial y no selectivo.
- Es un medio enriquecido porque lleva como aditivo principal 5-10% de sangre sobre una base de agar. Ambos compuestos contienen muchos nutrientes que permiten que en él puedan crecer la mayoría de las bacterias cultivables.
- Ese crecimiento ocurre sin restricción, por eso es no selectivo. Sin embargo, si se le adicionan compuestos que impidan el crecimiento de algunos microorganismos y favorezca el de otros, se vuelve selectivo. Por ejemplo, si se añaden ciertos tipos de antibióticos o antifúngicos.
- Es diferencial, ya que permite distinguir 3 tipos de bacterias: los beta-hemolíticos, alfa-hemolíticos y gamma-hemolíticos.
- Los beta-hemolíticos son aquellos que tienen la capacidad de lisar o romper completamente los glóbulos rojos, formando un halo claro alrededor de las colonias, por tanto producen hemólisis ß o ß-hemólisis, y los microorganismos son llamados ß-hemolíticos. Ejemplos de bacterias ß-hemolíticas son Streptococcus pyogenes y Streptococcus agalactiae.
- Los alfa-hemolíticos son los que realizan una hemólisis parcial, donde la hemoglobina es oxidada a metahemoglobina, generándose una coloración verdosa alrededor de las colonias. Este fenómeno se conoce como hemólisis α o α-hemólisis, y a las bacterias se les clasifica como α-hemolíticos. Ejemplo de bacterias α-hemolíticos son Streptococcus pneumoniae y Streptococcus del grupo viridans.
- Las bacterias gamma-hemolíticas o no hemolíticas crecen sobre el agar sin generar cambios en el mismo, efecto conocido como γ-hemólisis, y los microorganismo son γ-hemolíticos. Ejemplo de bacterias γ-hemolíticas: algunas cepas de Streptococcus del grupo D (Streptococcus bovis y Enterococcus faecalis).
Usos
- Este medio de cultivo es uno de los más comúnmente utilizados en el laboratorio de microbiología. Entre los microorganismos capaces de crecer en este medio se tienen: bacterias aerobias estrictas, facultativas, microaerófilas, anaerobias, grampositivas o gramnegativas, bacterias de crecimiento rápido o crecimiento lento.
- También crecen algunas bacterias exigentes o fastidiosas desde el punto de vista nutricional, así como hongos y levaduras. Es útil para realizar subcultivos o reactivar cepas que metabólicamente estén muy débiles.
Sin embargo, la elección del tipo de sangre y del agar base variará dependiendo del microorganismo probable que se sospecha recuperar y al uso que se le va a dar a la placa (cultivo o antibiograma).
Elección del tipo de sangre
La sangre puede ser de cordero, conejo, caballo o humana.
La más recomendada es la sangre de cordero, salvo algunas excepciones. Por ejemplo, para aislar especies de Haemophilus, donde la sangre recomendada es la de caballo o conejo, ya que la sangre de cordero posee enzimas que inhiben el factor V.
La menos recomendada es la humana, aunque es la más usada, quizás por ser la más fácil de obtener.
La sangre debe ser desfibrinada, obtenida sin ningún tipo de aditivo y proveniente de animales sanos. Para el uso de la sangre humana hay que tener presente varios factores:
- Si la sangre proviene de individuos que han padecido infecciones bacterianas, estas poseerán anticuerpos específicos. En estas condiciones es probable que se inhiba el crecimiento de algunas bacterias.
- Si se obtiene del banco de sangre, esta contiene citrato y es posible que ciertas bacterias no se desarrollen en su presencia.
- Si la sangre proviene de pacientes que están tomando antibióticos, puede inhibirse el crecimiento de bacterias susceptibles.
- Y si la sangre es de una persona diabética, el exceso de glucosa interfiere en que se desarrollen adecuadamente los patrones de hemólisis.
Elección del tipo de agar base
El agar base utilizado para la preparación del agar sangre puede ser muy amplio. Entre ellos se tienen: agar nutriente, agar infusión cerebro corazón, agar soya tripticasa, agar Müeller Hinton, agar Thayer Martin, agar Columbia, agar Brucella, agar Campylobacter, etc.
Usos del agar sangre de acuerdo al medio base utilizado para su preparación
Agar nutriente
Esta base es la menos utilizada, porque crecerán principalmente bacterias no exigentes, como bacilos entéricos, Pseudomonas sp, S. aureus, Bacillus sp, entre otros. No es recomendable para aislar Streptococcus.
Agar infusión cerebro corazón (BHI)
Es uno de los más utilizados como base, porque posee los nutrientes necesarios para el crecimiento de la mayoría de las bacterias, incluyendo Streptococcus sp y otras bacterias exigentes. Aunque no es apropiado para observar patrones de hemólisis.
Con esta base generalmente se usa sangre de cordero.
También se puede preparar variantes de agar sangre, donde se adicionan otros compuestos para aislar determinados microorganismos. Por ejemplo, el agar infusión cerebro corazón suplementado con sangre de conejo, cistina y glucosa, sirve para aislar Francisella tularensis.
En tanto que, con cistina telurito, es útil para aislar Corynebacterium diphteriae. Se puede usar sangre humana o de cordero.
Con la primera, la beta-hemólisis se verá como un halo estrecho, mientras que con la segunda el halo será mucho más amplio.
Esta base, junto con bacitracina, almidón de maíz, sangre de caballo y otros suplementos de enriquecimiento (IsoVitaleX), se usa para el aislamiento del género Haemophilus sp a partir de muestras respiratorias.
Si se le adiciona la combinación de antibióticos cloranfenicol-gentamicina o penicilina-estreptomicina con sangre de caballo, sirve para aislar hongos patógenos exigentes, incluso con un rendimiento superior al agar Sabouraud glucosa. Especialmente es útil en el aislamiento de Histoplasma capsulatum.
Agar soya tripticasa
Esta base es la más recomendada para observar mejor el patrón de hemólisis y la realización de pruebas diagnósticas, como taxos de optoquina y bacitracina. Es el agar sangre clásico que se usa de rutina.
Con esta base también se puede preparar el agar sangre especial para Corynebacterium diphteriae, con cistina telurito y sangre de cordero.
La combinación de este agar con sangre de cordero, más kanamicina-vancomicina, es ideal para el crecimiento de anaerobios, especialmente Bacteroides sp.
Agar Müeller Hinton
Esta base suplementada con sangre se usa para realizar el antibiograma de microorganismos exigentes, como Streptococcus sp. También es útil para aislar bacterias como Legionella pneumophila.
Agar Thayer Martin
Este medio es ideal como base del agar sangre cuando se sospecha del género Neisseria, especialmente Neisseria meningitidis, ya que N. gonorrhoeae no crece en agar sangre. También sirve para realizar las pruebas de susceptibilidad a Neisseria meningitidis.
Agar Columbia
Esta base es excelente para sembrar muestras de biopsias gástricas en busca de Helicobacter pylori.
El medio se prepara adicionando 7% de sangre de cordero desfibrinada con antibióticos (vancomicina, trimetoprim, anfotericina B y cefsulodin) para restringir el crecimiento de otros tipos de bacterias que puedan estar presentes.
Esta misma base suplementada con sangre humana o de cordero, ácido nalidíxico y colistina es útil para aislar Gardnerella vaginalis. También es ideal para evaluar la susceptibilidad antimicrobiana a los antibióticos del mismo microorganismo.
Además, sirve para la preparación de agar sangre para el cultivo de anaerobios, adicionando aminoglucósidos y vancomicina. Esta base permite observar adecuadamente los patrones de hemólisis.
Agar Brucella
Este medio usado como base del agar sangre, junto con la adición de vitamina K, es ideal para el cultivo de bacterias anaerobias. En este caso se recomienda el uso de sangre de cordero.
Agar Campylobacter
Agar Campylobacter suplementado con 5% de sangre de carnero y 5 antibióticos (cefalotina, anfotericina B, trimetoprima, polimixina B y vancomicina), es el medio utilizado para aislar Campylobacter jejuni en muestras de heces.
Preparación
Cada casa comercial trae al reverso del envase las indicaciones para preparar un litro de medio de cultivo. Se pueden hacer los cálculos correspondientes para preparar la cantidad deseada, según el agar base seleccionado.
Pesar y disolver
El agar base viene deshidratado (en polvo), por tanto debe disolverse en agua destilada ajustada a pH 7,3.
Se pesa la cantidad que indique el agar base escogido y se disuelve en la cantidad de agua correspondiente en una fiola, luego se calienta a fuego moderado y se mezcla con movimientos rotativos hasta disolver todo el polvo.
Esterilizar
Una vez disuelto, esterilizar en autoclave a 121°C por 20 minutos.
Agregado de la sangre
Al salir del autoclave se dejar enfriar la fiola hasta que la temperatura oscile entre 40 a 50 °C. Es una temperatura que soporta la piel humana, y a la vez el agar aun no se ha solidificado.
Para ello, se toca la fiola con la mano y si el calor es tolerable, es la temperatura ideal para agregar la cantidad de sangre desfibrinada correspondiente (50 ml por cada litro de agar). Mezclar suavemente para homogeneizar.
El paso del agregado de la sangre es crucial, pues si se realiza cuando el medio está muy caliente los glóbulos rojos se romperán y el medio no servirá para observar hemólisis.
Si se agrega demasiado frío, se formarán grumos y la superficie del medio no quedará lisa para poder hacer el estriado adecuadamente.
Verter en las placas de Petri
Servir en placas de Petri estériles inmediatamente después de homogeneizar la sangre. En cada placa de Petri se vierte aproximadamente 20 ml. Este procedimiento se realiza en una campana de flujo laminar o cerca del mechero.
Al momento de servir el agar sangre en las placas de Petri no deben quedar burbujas de aire en la superficie de la placa. Si esto sucede se pasa la llama del mechero de Bunsen rápidamente sobre la placa para eliminarlas.
Las placas se dejan solidificar y se guardan en nevera (2-8°C) de forma invertida hasta su uso. Antes de usar las placas de agar sangre se deben atemperar para poder sembrarse.
Las placas preparadas tienen una duración aproximada de 1 semana.
Referencias
- Bayona, M. Condiciones microbiológicas para el cultivo de Helicobacter pylori. Rev. Col. Gastroenterol.
- Forbes, B,, Sahm, D., Weissfeld, A. Diagnóstico Microbiológico de Bailey & Scott. Editorial Panamericana S.A.